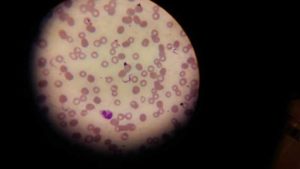

(UTV| කොළඹ) – ශ්රී ලංකාව තුළ මෙතෙක් වාර්තා වී නොමැති ට්රිපනසොමා නම් සුනඛ රෝගයක් මේ වනවිට මෙරටින් වාර්තා වී ඇති බව පේරාදෙණිය විශ්ව විද්යාලයේ පශු වෛද්ය පීඨයේ මහාචාර්ය අසෝක දංගොල්ල මහතා පවසයි.
එහි ඇති භයානකත්වය වන්නේ මෙම රෝගී තත්ත්වය මිනිසුන්ට වැළඳීමේ අවධානමක් ඇති බවත් , මේ වනවිට බලන්ගොඩ සහ මුලතිව් ප්රදේශයේ සුනඛයන් දෙදෙනෙක්ගෙන් මෙම රෝගී තත්වය හඳුනාගෙන ඇති බවට වැඩිදුර තොරතුරු වාර්තා වෙයි.
ඇස්වල රෝගී තත්ත්වයක් පැවති සුනඛයෙකු බලන්ගොඩ ප්රදේශයෙන් හමුවී ඇති අතර එම සුනඛයා වැඩිදුර පරීක්ෂණ කටයුතු සඳහා පේරාදෙණිය පශු ශික්ෂණ රෝහලට යොමු කිරීමේදීයි මෙම තත්වය හඳුනාගෙන තිබේ.
කෙසේ වෙතත් මෙම රෝගය පැතිරීමට දායකවන වාහකයා වූ Testse Fly නමැති මැස්සන් වර්ගය මේ වනතෙක් මෙරටින් හමුව නොමැති බවයි තොරතුරු වාර්තා වෙයි.
එහිදී සැක පළකරන්නේ කියුලෙක්ස් (Culex) නම් මදුරුවා සහ රාත්රියට පමණක් එළියට පැමිනෙන කිසින් බග් (Kissing Bug) නැමැති සතුන් මෙම රෝගය පතුරවන බවටයි.
මෙම රෝගය වැළඳුනු සුනඛයන්ගේ රෝග ලක්ෂණ ලෙස පශු වෛද්යවරු පෙන්වාදෙන්නේ අලස බව, ඇස් පෙනීම දුර්වල වීම හෝ අන්ධ වීම, ඇස් සුදු පැහැ වීමයි.
[alert color=”faebcc” icon=”fa-commenting”] රටේ ලෝකයේ සිදු වන සිදුවීම් එසැණින් දැන ගන්න UTV alerts සක්රීය කරගන්න.[textmarker color=”8a6d3b”] UTV alerts සක්රීය කිරීමට .REG <හිස්තැනක් > utv ලෙස සටහන් කර 77000 ට [/textmarker] යොමුකිරීමෙන් මෙම උණුසුම් පුවත් ඔබට දැන් ලබා ගත හැක [/alert
